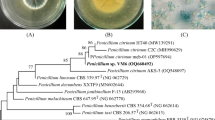

Abstract
A fungal isolate out of 22 endophytic fungi, isolated from the different parts of medicinal plant Gloriosa superba, was subjected to bioassay guided fractionation. This fractionation resulted in the isolation of a novel bioactive metabolite along with three other known compounds. The structures of compounds were assessed on the basis of their spectroscopic analysis. Isolated compounds were also assayed for their biological potential. Compounds, in comparison to standard antimicrobial agents, were tested for their antimicrobial activity against five human pathogenic bacteria: Staphylococcus aureus (MTCC 96), Bacillus subtilis (MTCC 2451), Escherichia coli (MTCC 82), Pseudomonas aeruginosa (MTCC 2642), and Salmonella typhimurium (MTCC 1251), and three pathogenic fungal strains: Saccharomyces cerevisiae (MTCC 172), Candida albicans (MTCC 3018), and Cryptococcus gastricus (MTCC 1715). The compounds were also evaluated for their anticancer potential against six cancer cell lines, viz., A-549, HEP-2, MCF-7, OVCAR-5, THP-1, and CVI-1. Compound 4 which is isolated for first time from any endophytic fungi, exhibited significant antimicrobial and cytotoxic activity. All the fungal strains were considerably inhibited by the compound. Leukemic cancer cell line THP-1 and Breast cancer cell line: MCF-7 were significantly inhibited by 2 and 4. Compound 4 inhibited these cell lines with IC50 30 μg/mL and 50 μg/mL, respectively, and was found to possess potency comparable to standard anticancer agents Mitomycin-c and 5-FU. Compound 4 also inhibited Lung cancer cell line—A-549 and CV-1.
Similar content being viewed by others
Avoid common mistakes on your manuscript.
Introduction
Bioprospecting refers to the search for novel products of economic importance, from plant or microbial sources (Stinson et al., 2003). Natural products have been exploited for human use for thousands of years, and plants have been the chief source of compounds of medicinal use. Plants have been found to be associated with microorganisms which are capable of producing molecules possessing remarkable biological activities. Microorganisms can serve as reliable, reproducible, and inexhaustible source of novel structures, bearing pharmaceutical potential. Microorganisms that live in the intercellular spaces of different parts of plants causing no evident expression of their presence are called “Endophytes” (Lu et al., 2000). The relationship between plant and endophyte is found to be mutualistic, the former being protector and feeder for the latter which in return produces bioactive substances that provides protection to plant and also enhance the growth and competitiveness of the host in nature (Strobel, 2002). Webber (1981) was probably the first researcher to report an example of plant protection given by an endophytic fungus, in which the endophyte Phomopsis oblonga protected elm trees against the beetle Physocnemum brevilineum. Endophytes also promote plant growth by a number of mechanisms such as phosphate solubilization activity (Verma et al., 2001; Wakelin et al., 2004), the production of a siderophore (Costa and Loper, 1994), by supplying biologically fixed nitrogen (James et al., 1994), and by supplying essential vitamins to plants (Pirttila et al., 2004). Other beneficial effects of endophytes on plant growth include osmotic adjustment, stomatal regulation, modification of root morphology, enhanced uptake of minerals and alteration of nitrogen accumulation, and metabolism (Compant et al., 2005).
In the present study, 22 endophytic fungi from the different parts of medicinal plant Gloriosa superba were isolated and one strain belonging to Aspergillus spp., isolated from the seeds of G. superba was found to produce an alkaloidal constituent that showed significant antifungal and antitumor activities. G. superba L. is a perennial climber and is used as an ayurvedic medicinal herb to cure diseases in various parts of Africa and Southeast Asia (Ghosh et al., 2002). The plant was under threatened category due to its extensive uprooting as the plant is used by medicinal industries for its colchicine content. The plant is used to cure various ailment like arthritis, gout, rheumatism, inflammation, ulcers, bleeding piles, skin diseases, leprosy, etc. (Jana and Shekhawat, 2011).
Materials and methods
Plant sample collection
Freshly collected, mature, healthy parts of G. superba were collected and authenticated by Dr. K. Mahadeva Chetty, Head, Department of Botany, S.V. University, Tirupati, India. Samples were transported in sterile plastic bags, stored overnight at 4 °C, and processed within 48 h.
Isolation and extraction of endophytic fungi
Plant samples, were washed under running tap water for 10 min, to remove the attached debris. Samples were successively surface sterilized by the method given by Petrini et al. (1992) with slight modification for different parts. Plant tissues were immersed in 70 % (v/v) ethanol for 1–3 min followed by washing with 5 % aqueous solution of sodium hypochlorite for 2–5 min, and again in 70 % ethanol for 30 s. All parts were finally washed thrice with sterile distilled water to remove excess sterilant and dried aseptically. Sterilized plant parts were cut longitudinally and then placed on Petri dishes containing Sabouraud dextrose agar medium with chloramphenicol. Petri dishes were incubated at 28 °C until the outgrowth of endophytic fungi was detected. Pure cultures were then transferred to PDA plates and cultivated for 14 days at 28 °C. Then three plugs (8 mm in diameter) of each fungal isolate were inoculated in 500-mL Erlenmeyer flask (four flasks for each culture) containing potato dextrose broth and were kept in a shaker incubator at 27°, 120 rpm. After 7–10 days of fermentation, culture broth of each isolate was filtered and filtrate was extracted with water followed by extraction with n-butanol and chloroform. Extracts were evaporated to dryness under reduced pressure at 45 °C using a rotary vacuum evaporator. After preliminary studies for biological potential of extracts (Budhiraja et al., 2012) and test for the presence of alkaloid when sprayed with Dragendorff’s reagent, one isolate (FE-19) was selected for further investigation. Residue (4.2 g) obtained from extraction of selected strain was subjected to column chromatography and elution was done with increasing percentage of ethyl acetate in hexane. Fractions of each distinct polarity were pooled to obtain ten different fractions. Draggendorf positive fractions were pooled and concentrated to give 120 mg of residue. This mixture was rechromatographed further on silica gel and eluted with increasing percentage of methanol in chloroform. The fractions showing positive tests for alkaloids were pooled and crystallized (30 mg). Three other compounds with different R f were also isolated and identified after column chromatography.
Chemical analysis
The structure of compounds isolated by the column chromatography of the extract were identified by different sophisticated spectroscopic techniques 1H, 13C nuclear magnetic resonance (NMR), and DEPT spectra were recorded on a Bruker DRX400 spectrometer using TMS as an internal standard and chemical shifts were recorded as δ (parts per million) values and coupling constants, J in Hz. Mass spectra were recorded on a Bruker Esquire 3000 plus mass spectrometer. Melting points were determined on a Buchi–Tottoli apparatus. The optical rotation of compounds was measured using a Perkin-Elmer 341 polarimeter with a tube of 10-cm cell path length using dichloromethane as solvent.
Identification of endophyte
The selected fungal isolate was grown in PDB for 5 days at 28 °C. The mycelium was filtered from the broth (5 days old) and weighed. DNA was extracted and purified using the CTAB method (Saghai-Maroof et al., 1984). For identification and differentiation, the Internal Transcribe Spacer regions (ITS1 and ITS2) and the intervening 5.8S r RNA region was amplified. The ITS regions of the fungus were amplified by PCR (Eppendorf Mastercycler® pro thermal cycler) and the universal ITS primers, ITS1 (5′-TCC GTA GGT GAA CCT GCG G-3′) and ITS4 (5′-TCC TCC GCT TAT TGA TATGC-3′). Initial denaturation was done at 95 °C for 30 s, primer annealing at 55 °C, and extension at 72 °C for 7 min. The PCR products were purified, quantified, and subjected to sequencing.
Antimicrobial assay
The compounds isolated after the column chromatography of fungal extract were tested for antimicrobial activity by disk diffusion method. Standard microbial strains, for assay were procured from IMTECH, Chandigarh. Antimicrobial activity of compound was established in triplicate against five human pathogenic bacteria: Staphylococcus aureus (MTCC 96), Bacillus subtilis (MTCC 2451), Escherichia coli (MTCC 82), Pseudomonas aeruginosa (MTCC 2642), and Salmonella typhimurium (MTCC 1251), and three pathogenic fungal strains: Saccharomyces cerevisiae (MTCC 172), Candida albicans (MTCC 3018), and Cryptococcus gastricus (MTCC 1715). The antibacterial activity of compounds was determined with comparison to standard antibiotic disks of Amoxicillin (5 μg) and Gentamycin (10 μg). Pre-warmed Mueller–Hinton agar plates were inoculated with 106 CFU/mL of test bacteria. Each compound was dissolved in DMSO (2 mg/mL) and then 30 μL of each was pipetted onto sterile paper disks (6-mm diameter) placed on the surface of inoculated agar plates. Plates were incubated at 37 °C for 24 h. For determining antifungal activity of compounds, fungal cultures were grown in Sabouraud dextrose agar with chloramphenicol medium and kept at 26 °C for 48 h. Fluconazole (10 μg) disks were used as standard antifungal to compare the antifungal activity of compounds. Antimicrobial activity was expressed as the diameter of the inhibition zone (mm) produced by the compounds. DMSO was used as negative control. MIC of 4 was evaluated according to the method described by Yean et al. (2009). Single colony of microbial strains growing in agar medium was inoculated in test tubes containing nutrient broth (bacterial strains) and fungal strains were inoculated in Sabouraud dextrose broth. The initial optical density (OD) of the medium was measured by spectrophotometer at 600 nm. The test strains were incubated until the OD reached 0.4–0.6. Then the different concentrations of 4 (6.25, 12.5, 25, 50, 100, 200, and 400 μg/mL) were tested for the inhibition of growth of these microbes, in separate tubes. DMSO was used as a negative control. The 10-mL tubes each containing 1 mL of different concentration of 4 were incubated with shaking at 220 rpm using a rotary shaker. The OD at 600 nm was measured after 30 min, for 3 h.
In vitro cytotoxicity against human cancer cell lines
Compounds were also evaluated for cytotoxic potential and their effect to inhibit the growth of cancer cell lines, A-549, HEP-2, MCF-7, OVCAR-5, THP-1, and CVI-1, was tested. The procedure recommended by the National Cancer Institute, that uses the protein-A binding dye sulforhodamine B to estimate cell growth was followed for in vitro anticancer activity screening. Cells in their log phase were harvested, counted, and seeded (102 cells/well in 100 mL medium) in 96-well microtitre plates. After 24 h of incubation at 37 °C and 5 % CO2 to allow cell attachment, cultures were treated with varying concentrations (10–100 μM) of compound isolated after column chromatography. Four replicate wells were set up for each experimental condition and were left in contact with the cells for 48 h under same conditions. Thereafter, cells were fixed with 50 % chilled TCA and kept at 4 °C for 1 h, washed, and air-dried. Cells were stained with sulforhodamine B dye. The adsorbed dye was dissolved in Tris-buffer and the plates were gently shaken for 10 min on a mechanical shaker. The OD was recorded on ELISA reader at 540 nm. The cell growth was calculated by subtracting mean OD value of the respective blank from the mean OD value of experimental set. Percentage of growth in the was calculated considering the growth in the absence of any test material as 100 % and in turn percent growth inhibition in presence of compound was calculated. (Monks et al., 2005; Skehan et al., 1990).
Results
Twenty-two fungal isolates belonging to different species were isolated from the surface sterilized parts of medicinal plant were isolated and screened for the presence of some potent molecules. A fungal isolate belonging to Aspergillus species, isolated from the seeds of G. superba, was subjected to column chromatography for isolation of some biologically active compound. Four different compounds with different polarity were obtained and were assessed for their bioactive potential. Fungal strain producing these metabolites was identified by amplifying and sequencing the ITS regions. Sequences of the strains were compared with ITS and rDNA D1/D2 sequence data from strains available at the public databases Genbank (http://www.ncbi.nem.nih.gov) by the BLASTn sequence match routines. Sequences determined in this study were deposited to GenBank using the Sequin software with GenBank accession no. JN662374.
Structure determination of compounds
Four compounds (Fig. 1) were isolated from the fungal extract. Out of the four, three compounds (5-(hydroxymethyl) furan-2-carbaldehyde, 4-hydroxyphthalic acid dimethyl ester, and ergosterol were known compounds and one compound (colchatetralene) was unknown. The spectral data of the all the known compounds were found to match the spectral data reported in the literature (Haque et al., 2005; Klemke et al., 2004). The spectral data of the unknown compound (closely related to colchicine, coded as KL-4) is discussed below.
6-Methyl-1,2,3-trihydroxy-7,8-cyclohepta-9,12-diene-11-one-5,6,7,8-tetralene-7-acetamide (KL-4)
The molecule is a structural analog of colchicine, and is not reported in the literature. The molecule coded as KL-4 was obtained as a white powder with a melting point of 161–163 °C, [α]17D + 2.73 (c = 0.69, dichloromethane). Molecular formula was determined to be C18H19NO5 by TOF MS ES + (m/3 353 [M + Na] + spectra. The 1H NMR spectrum showed a multiplet at δ 7.26 (2H, m) for the two protons attached to the β carbon (C-9, 13), an overlapped doublet along with a singlet merged to a multiplet at δ 6.06–6.22 (3H, m) for the protons at carbon (C-4, 10, 12). A doublet at δ 4.16 (1H, d, J = 7.4 Hz) for the proton at C-8 and the coupling constant at value of 7.4 Hz indicating vicinal coupling with the proton at C-9. Multiplets at δ 2.70 (1H, m) and δ 2.94 (1H, m) were found for the two non equivalent protons of the methylene at C-5, a singlet at δ 2.29 (3H, s) indicating the presence of methlyl group (NH–CO–CH3). A doublet at δ 1.25 (3H, d, J = 7.6 Hz) for the methyl attached to a C-6. The coupling constant of value 7.6 Hz suggests that it is coupling with the adjacent methine proton at C-6, and a multiplet at δ 1.35 (1H, m) for the methylene proton at C-6.
The 13C spectrum showed signals for the ketonic carbonyl at δ 188.65 (C-11) and amide carbonyl at δ 166.54. A signal at δ 143.88 for C-9, 13, and a signal at δ 137.43 for C-1,3. Signal at δ 130.22 for C-2, C-4a, and C-1a. A signal at δ 118 for C-4, a signal at δ 54 for the methine carbon at C-7, δ 51.95 for the methylene at C-5 which was also confirmed by DEPT spectrum. A signal at δ 42.65 for the methine carbon at C-6. δ 31.93 for the methane carbon at C-8. δ 24.87 for the methyl carbon attached to the amide carbonyl at δ 14.13 for the methyl carbon attached to C-6. DEPT spectra indicated a single inverse signal for the carbon with even no. of protons at δ 54, i.e., for the CH2 group at C-5. All the signals except the signals of the amide and ketonic carbonyl were observed as positive signals at δ 143.14, 137.43, 130.22, 118, 54, 42.65, 31.13, 24.87, and 14.13.
The Physical data of KL-4 is given below.
mp—161–163 °C. Anal. Calcd for C, 65.64; H, 5.81; N, 4.25; O, 24.29. Found C, 65.43; H, 5.98; N, 4.13. 1H NMR (CDCl3, 500 MHz, δ, TMS = 0) 7.26 (2H, m), 6.06–6.22 (3H, two overlapped doublet along with a singlet merged to a multiplet), 4.16 (1H, d) 2.70 (1H, m) 2.94 (1H, m) 2.29 (3H, s) 1.25 (3H, d), 1.35 (1H, m). 13C NMR (CDCl3, 125 MHz, δ, TMS = 0) 188.65, 166.54, 143.14, 137.43, 130.22, 118, 54, 51.95, 42.65, 31.93, 24.87, 14.13. Mass, M+ + Na: 353.
Antimicrobial activity
All compounds were assessed for their antimicrobial potential. Compounds KL-1 and KL-4 exhibited good antimicrobial spectrum. KL-3 also showed some inhibition of S. aureus and P. aeruginosa. KL-4, a novel fungal metabolite exhibited noticeable activity against all the fungal strains. Gram positive bacteria were also found to be susceptible to this compound, whereas no activity was observed against S. typhi. On the basis of zone of inhibitions (Table 1), MIC of KL-1 and KL-4 was calculated against all the test strains. KL-4 showed good antimicrobial spectrum against S. aureus, B. subtilis, E. coli, S. cerevisiae, C. albicans, and C. gastricus with MIC 25, 50, 100, 25, 12.5, and 50 μg/mL, respectively (Table 2).
Cytotoxic activity
KL-4 was tested for in vitro cytotoxic potential against six tumor cell lines. It exhibited broad-spectrum antitumor activities against different cell lines. Breast cancer cell line (MCF-7) and Leukemic cell line (THP-1) were significantly inhibited by the compound KL-4 (Table 3; Fig. 2).
Discussion
Microorganisms residing within the plant tissues not only receive their nutrition from the plant but also tend to reciprocate by providing the protection to their host by producing various antibiotics. Many bioactive compounds have been isolated from these residents of plants, but still they provide ample opportunity of producing newer biomolecules of great therapeutic value. Various species of genus Aspergillus have been isolated as endophytes from different plants and have been reported to produce compounds of significant biological interest. Aspergillus is a genus consisting of several hundred species found in various climates. Aspergillus was first documented in 1729 by the Italian priest and biologist Pier Antonio Micheli. Two alkaloids, 9-deacetylfumigaclavine and 9-deacetoxyfumigaclavine, having activity against human leukemia cells (K562) have been isolated from the culture of Aspergillus fumigates (Ge et al., 2009). A variant of Aspergillus niger has been obtained as an endophyte from Taxus cuspidate and was found to produce Taxol (Zhao et al., 2009). Aspergillus niger has been isolated from Rosa damacaena and was found to produce 2-Phenylethanol (Wani et al., 2010).
5HMF obtained as a metabolite of strain FE-19 in this study has earlier been isolated from the mangrove fungus Verruculina enaria from a salt lake in the Bahamas (Lin et al., 2002). HMF is also an important constituent of honey. Antimicrobial activity of honey against many pathogenic bacterial strains has been reported by many researchers, and this activity is believed to be due to the presence of HMF (Nafea et al., 2011; Badawy et al., 2004). HMF is an anti-sickling agent that specifically bind to intracellular sickle hemoglobin (HbS) without being inhibited by plasma and tissue proteins (Abdulmalik et al., 2005). 5HMF has been reported to possess moderate cytotoxicity against V79 cells and Caco-2 cells (Janzowski et al., 2005). Compound 3, ergosterol has been isolated from the fungal strain Neoplaconema napellum, obtained as an endophyte from leaves of Hopea hainanensis (Wang et al. 2006), and we isolated it again from Aspergillus sp. as a major metabolite. It has been found to possess antitumor activity (Yazawa et al., 2000; Takaku et al., 2001). It has also been used as a marker to estimate fungal biomass in soil and plant−fungal tissue samples (Richardson and Logendra 1997). Compound 4 is a new metabolite with antimicrobial and cytotoxic activity, and it also represents the first isolation of the tetralene derivative from the genus Aspergillus. Compound 4 in this report is isolated first time as a metabolite and appears to be a promising compound in the area of biological control.
References
Abdulmalik O, Safo MK, Chen Q, Yang J, Brugnara C, Ohene-Frempong K, Abraham DJ, Asakura T (2005) 5-hydroxymethyl-2-furfural modifies intracellular sickle haemoglobin and inhibits sickling of red blood cells. Br J Haematol 128:552–561
Badawy OFH, Shafii SSA, Tharwat EE, Kamal AM (2004) Antibacterial activity of bee honey and its therapeutic usefulness against Escherichia coli O157:H7 and Salmonella typhimurium infection. Rev Sci Technol Office Int Epiz 23:1011–1022
Budhiraja A, Nepali K, Kaul S, Dhar KL (2012) Antimicrobial and cytotoxic activities of fungal isolates of medicinal plant Gloriosa superba. Int J Recent Adv Pharm Res 2:1–9
Compant S, Duffy B, Nowak J, Barka EA (2005) Use of plant growth-promoting bacteria for biocontrol of plant diseases: principles, mechanisms of action, and future prospects. Appl Environ Microbiol 71:4951–4959
Costa JM, Loper JE (1994) Characterization of siderophore production by the biological-control agent Enterobacter cloacae. Mol Plant Microbe Interact 7:440–448
Ge HM, Yu ZG, Zhang J, Wu JH, Tan RX (2009) Bioactive alkaloids from endophytic Aspergillus fumigates. J Nat Prod. doi:10.1021/np800700e
Ghosh B, Mukherjee S, Jha TB, Jha S (2002) Enhanced colchicine production in root cultures of G. superba by direct and indirect precursors of the biosynthetic pathway. Biotechnol Lett 24:231–234
Haque MA, Hossain MS, Rahman MZ, Rahman MR, Hossain MS, Mosihuzzaman M, Nahar N, Khan SI (2005) Isolation of bioactive secondary metabolites from the endophytic fungus of Ocimum basilicum. Dhaka Univ J Pharm Sci 4(2):127–130
James EK, Reis VM, Olivares FL, Baldani JI, Dobereiner J (1994) Infection of sugar cane by the nitrogen-fixing bacterium Acetobacter diazotrophicus. J Exp Bot 45:757–766
Jana S, Shekhawat GS (2011) Critical review on medicinally potent plant species: Gloriosa superba. Fitoterapia 82:293–301
Janzowski C, Glaab V, Samimi E, Schlatter J, Eisenbrand G (2005) Hydroxymethylfurfural: assessment of mutagenicity, DNA-damaging potential and reactivity towards cellular glutathione. Food Chem Toxicol 38:801–809
Klemke C, Kehraus S, Wright AD, König GM (2004) New secondary metabolites from the marine endophytic fungus Apiospora montagnei. J Nat Prod 67:1058–1063
Lin Y, Wu X, Deng Z, Wang J, Vrijmoed S, Zhou LLP, Jones EBG (2002) The metabolites of the mangrove fungus Verruculina enalia No. 2606 from a salt lake in the Bahamas. Phytochemistry 59:469–471
Lu H, Zou WX, Meng JC, Hu J, Tan RX (2000) New bioactive metabolites produced by Colletotrichum sp., an endophytic fungus in Artemisia annua. Plant Sci 151:67–73
Monks A, Scudiero D, Skehan P, Shoemaker R, Paull K, Vistica D, Hose C, Langley J, Cronise P, VaigroWolff A, Gray-Goodrich M, Campbell H, Mayo J, Boyd M (2005) Feasibility of a highflux anticancer drug screen using a diverse panel of cultured human tumor cell lines. J Natl Cancer Inst 83:757–766
Nafea EA, Walaa AM, Asmaa, Fawzy M (2011) Does the HMF value affect the antibacterial activity of the bee honey. Egypt Acad J biol Sci 4:13–19
Petrini O, Sieber TN, Toti L, Viret O (1992) Ecology, metabolite production and substrate utilization in endophytic fungi. Nat Toxins 1:185–196
Pirttila A, Joensuu P, Pospiech H, Jalonen J, Hohtola A (2004) Bud endophytes of Scots pine produce adenine derivatives and other compounds that affect morphology and mitigate browning of callus cultures. Physiol Plant 121:305–312
Richardson MD, Logendra S (1997) Ergosterol as an indicator of endophyte biomass in grass seeds. J Agric Food Chem 45:3903–3907
Saghai-Maroof MA, Soliman KM, Jorgensen RA, Allard RW (1984) Ribosomal DNA spacer-length polymorphisms in barley: mendelian inheritance, chromosomal location, and population dynamics. Proc Natl Acad Sci USA 81:8014–8018
Skehan R, Storeng D, Scudiero A, Monks J, Mc Mohan D, Vistica JT, Warren H, Bokesch S, Kenney MR, Boyd M (1990) New colorimetric cytotoxic screening. J Natl Cancer Inst 82:1107–1111
Stinson M, Ezra D, Hess WM, Sears J, Strobel G (2003) An endophytic Gliocladium sp. of Eucryphia cordifolia producing selective volatile antimicrobial compounds. Plant Sci 165:913–922
Strobel GA (2002) Rainforest endophytes and bioactive products. Crit Rev Biotechnol 22:315–333
Takaku T, Kimura Y, Okuda H (2001) Isolation of an antitumor compound from Agaricus blazei Murill and its mechanism of action. J Nutr 131:1409–1413
Verma SC, Ladha JK, Tripathi AK (2001) Evaluation of plant growth promotion and colonization ability of endophytic diazotrophs from deep water rice. J Biotechnol 91:127–141
Wakelin S, Warren R, Harvey P, Ryder M (2004) Phosphate solubilization by Penicillium spp. closely associated with wheat roots. Biol Fert Soils 40:36–43
Wang FW, Ye YH, Chen JR, Wang XT, Zhu HL, Song YC, Tan RX (2006) Neoplaether, a new cytotoxic and antifungal endophyte metabolite from Neoplaconema napellum IFB-E016. FEMS Microbiol Lett 261:218–223
Wani MA, Kaul S, Dhar MK, Dhar KL (2010) GC–MS analysis reveals production of 2-Phenylethanol from Aspergillus niger endophytic in rose. J Basic Microbiol 50:110–114
Webber R (1981) A natural control of Dutch elm disease. Nature 292:449–451
Yazawa Y, Yokota M, Sugiyama K (2000) Antitumor promoting effect of an active component of Polyporus, ergosterol and related compounds on rat urinary bladder carcinogenesis in a short-term test with concanavalin A. Biol Pharm Bull 23:1298–1302
Yean HC, Atong M, Chong KP (2009) Lettucenin A and its role against Xanthomonas campestris. J Agr Sci 1:87–93
Zhao K, Ping W, Li Q, Hao S, Zhao L, Gao T, Zhou D (2009) Aspergillus niger var. taxi, a new species variant of taxol-producing fungus isolated from Taxus cuspidate in China. J Appl Microbiol 107:1202–1207
Acknowledgments
The authors express their gratitude to Mr. Praveen Garg, chairman, I.S.F College of pharmacy, Moga for providing facilities in the college. Authors are extremely thankful to Dr. Manoj Kumar Dhar, Director School of Biotechnology, Jammu University, India and Dr. Sanjna Kaul, Associate Professor, Department of Microbiology, Jammu University, India, for providing facilities for molecular studies of fungal isolates.
Conflict of interest
Authors declare no conflict of interest.
Author information
Authors and Affiliations
Corresponding author
Rights and permissions
About this article
Cite this article
Budhiraja, A., Nepali, K., Sapra, S. et al. Bioactive metabolites from an endophytic fungus of Aspergillus species isolated from seeds of Gloriosa superba Linn.. Med Chem Res 22, 323–329 (2013). https://doi.org/10.1007/s00044-012-0032-z
Received:
Accepted:
Published:
Issue Date:
DOI: https://doi.org/10.1007/s00044-012-0032-z